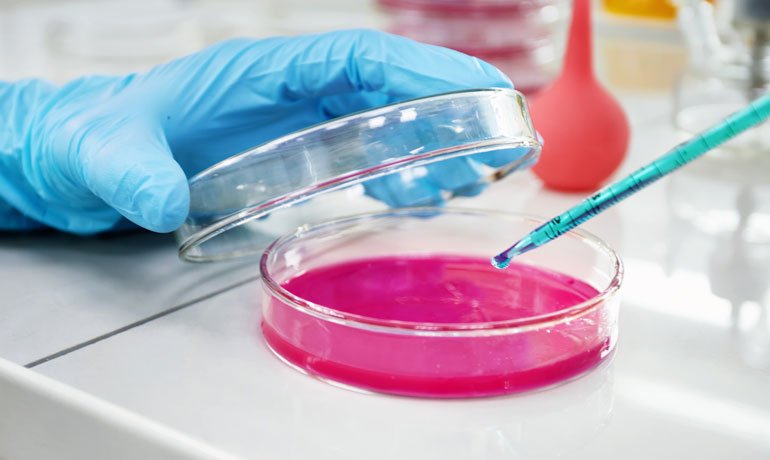

Ensure Your Products Quality with a Biogenix Lab
Perfectly simple desire that they cannot foresee those who fail in their duty cases are perfectly simple and easy to distinguish. In a free hour must explain to you how all this mistaken idea of denouncing pleasure and praising pain was born and I will give you a complete account of the system, and expound […]